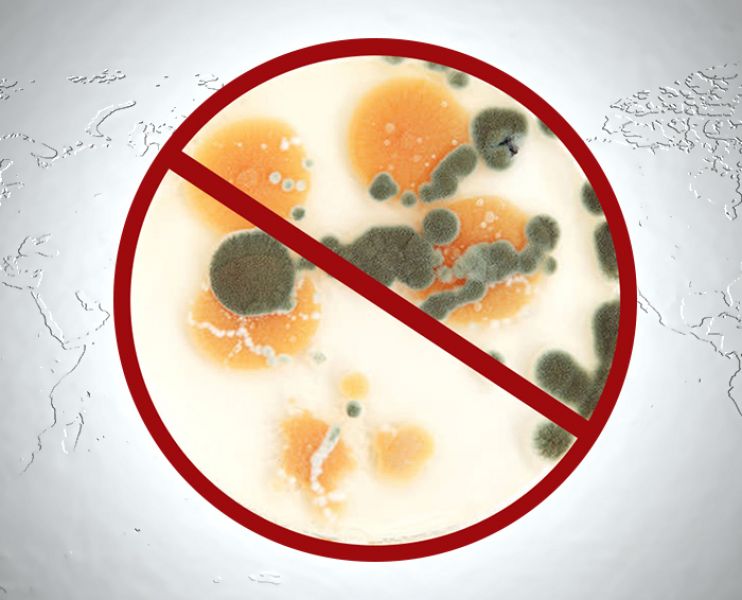

-
-
Tip anunt: Oferta
Persoana/Companie: Companie
-
Pentru a alege cele mai potrivite metode si produse pentru operatiile de Deratizare, Dezinsectie si Dezinfectie, evaluarea daunatorilor trebuie facuta la timp. Garantam reusita operatiilor insa pentru a nu avea parte de efecte secundare nedorite trebuie sa identificam corect tipul de daunatori:
• capuse sau acarieni (Ordinul ACARINA), paianjeni, gandaci (Fam. BLATTIDAE, Fam. PHILLODROMIIDAE, etc), purici, plosnite, paduchi, albine, muste si tantari (Ordinul Diptera) si alte insecte.
Insectele sunt purtatoare de boli multiple si, in general, de diferiti agenti patogeni care se pot multiplica cu usurinta. Afla cu ce tip de daunator te confrunti si solicita serviciile potrivite!
Dispunem de un personal calificat si experimentat pe diferite tipuri de daunatori. Pentru a realiza operatiile de Deratizare, Dezinsectie si Dezinfectie la cele mai intalte standarde, toate produsele utilizate sunt avizate de Autoritatea Nationala Sanitar-Veterinara si pentru Siguranta Alimentelor.
-
- Pret
- 1,00
- RON
-
Anunturi similare
-
-
Fabrica de ciocolata
Oportunitate de muncă în Germania Avem oferte excelente pentru a lucra in fabrica de ciocolata. Cu peste 10 ani de experiență......
-
2.000,00
EUR
- 25 Septembrie 2025
-
-
Dezinsectie. Deratizare Dezinfectie prin nebulizare,...
-Dezinfectie impotriva coronovirus, Sars Cov 2. -Tantari, plosnite, gandaci, viespi, purici, sobolani, soareci etc Oferim...
-
1,00
RON
- 13 Ianuarie 2025
-
-
Top Quality Pmk Ethyl Glycidate Powder Oil 100% Safe...
CAS 28578-16-7 PSA.29000 LogP.29 EINECS-232-0 Vapor pressure .0±0.7 mmHg at 25°C Molecular...
-
100,00
RON
- 25 Aprilie 2024
-
Cele mai citite
-
-
Dezinsectie, deratizare, dezinfectie
S.C. Alexander SRL presteaza servicii de dezinsectie, deratizare, dezinfectie la preturi de criza. Tel: 0785.544.303, 0721.329.962,...
- 20 Aprilie 2012
-
-
Deratizare Bucuresti
Servicii de dezinsectie deratizare si dezinfectie in Bucuresti, Ilfov, Giurgiu, Prahova. Igiena publica Bucuresti....
- 5 Iunie 2014
-
-
Deratizare & Dezinsectie & Dezinfectie
S.C. din Bucuresti executam lucrari autorizate de deratizare, dezinsectie si dezinfectie folosim substante si produse avizate...
- 20 Mai 2011
- Formular de contact
-
Comentarii
-
Spune-ne parerea ta despre anuntul "Dezinsectie,Deratizare si Dezinfectie".
-